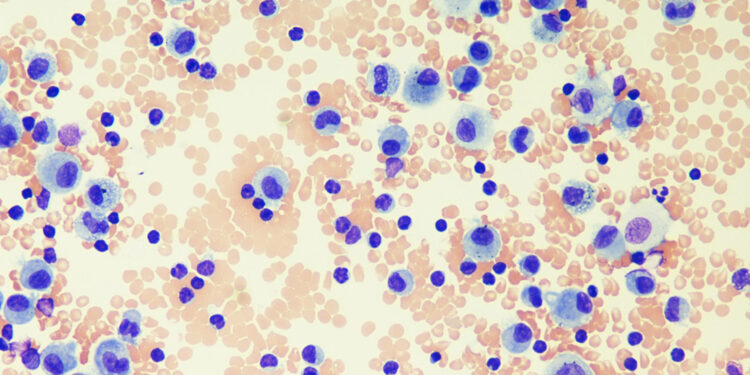

A Faculdade de Medicina da Universidade do Porto (FMUP) anunciou o lançamento de um e-book intitulado “Doenças Pulmonares Difusas: Aplicações da Lavagem Broncoalveolar (BAL)”. A obra, que será disponibilizada em acesso livre, visa aprofundar o conhecimento sobre a utilização da lavagem broncoalveolar no diagnóstico e avaliação de doenças pulmonares difusas, um tema relevante na prática médica contemporânea.
O e-book é resultado de uma colaboração entre especialistas da FMUP e está destinado a profissionais de saúde, estudantes e pesquisadores na área da pneumologia. Segundo os organizadores, a publicação busca não apenas compartilhar informações técnicas, mas também promover uma compreensão mais ampla das condições respiratórias que afetam um número crescente de pacientes.
A FMUP enfatiza a importância do acesso a informações científicas de qualidade, especialmente em áreas que envolvem diagnósticos complexos como as doenças pulmonares. O material está disponível no site oficial da faculdade e pode ser baixado gratuitamente por todos os interessados.
Além do e-book, a FMUP planeja realizar uma série de webinars e discussões online para complementar o aprendizado sobre o tema, promovendo um espaço interativo para troca de conhecimento e experiências entre profissionais da saúde.
Origem: Universidade do Porto